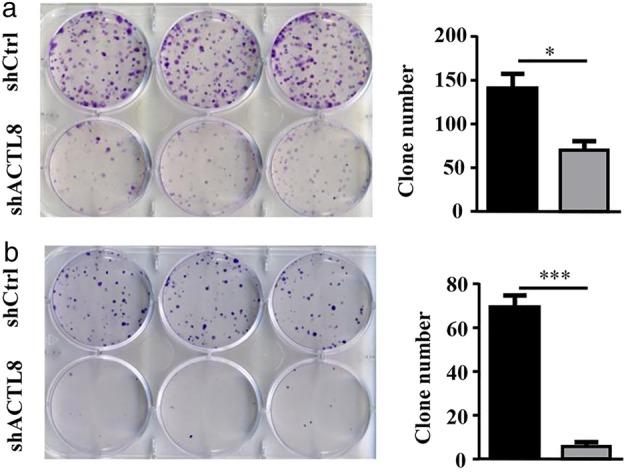
https://cdn.ncbi.nlm.nih.gov/pmc/blobs/a887/7049497/6530034920d5/TCA-11-526-g005.jpg

肌动蛋白样蛋白 8 促进肺腺癌细胞的增殖、集落形成、促血管生成、迁移和侵袭。
Actin-like protein 8 promotes cell proliferation, colony-formation, proangiogenesis, migration and invasion in lung adenocarcinoma cells.
机构信息
Department of Thoracic Surgery, Peking University China-Japan Friendship School of Clinical Medicine, Beijing, China.
Department of Pathology, China-Japan Friendship Hospital, Beijing, China.
出版信息
Thorac Cancer. 2020 Mar;11(3):526-536. doi: 10.1111/1759-7714.13247. Epub 2020 Jan 21.
BACKGROUND
Non-small cell lung cancer (NSCLC) is the leading cause of cancer-associated mortality worldwide of which lung adenocarcinoma (LUAD) is the most common. The identification of oncogenes and effective drug targets is the key to individualized LUAD treatment. Actin-like protein 8 (ACTL8), a member of the cancer/testis antigen family, is associated with tumor growth and patient prognosis in various types of cancer. However, whether ACTL8 is involved in the development of LUAD remains unknown. The aim of the present study was to demonstrate the role of ACTL8 in human LUAD cells.
METHODS
The expression of ACTL8 in LUAD tissues and cell lines was assessed using immunohistochemistry and western blotting. Additionally, plasmids expressing ACTL8-specific short hairpin RNAs were used to generate lentiviruses which were subsequently used to infect A549 and NCI-H1975 human LUAD cells. Cell proliferation, migration, invasion and apoptosis, as well as cell cycle progression and the expression of protein markers of epithelial to mesenchymal transition were investigated. A549 cell tumor growth in nude mice was also examined.
RESULTS
The results showed that ACTL8 was highly expressed in A549 and NCI-H1975 LUAD cell lines. Additionally, ACTL8-knockdown inhibited proliferation, colony formation, cell cycle progression, migration and invasion, and increased apoptosis in both cell lines. Furthermore, in vivo experiments in nude mice revealed that ACTL8-knockdown inhibited A549 cell tumor growth.
CONCLUSION
These results suggest that ACTL8 serves an oncogenic role in human LUAD cells, and that ACTL8 may represent a potential therapeutic target for LUAD.
KEY POINTS
Our results suggest that ACTL8 serves an oncogenic role in human LUAD cells, and that ACTL8 may represent a potential therapeutic target for LUAD.
背景
非小细胞肺癌(NSCLC)是全球癌症相关死亡的主要原因,其中肺腺癌(LUAD)最为常见。鉴定致癌基因和有效的药物靶点是LUAD 个体化治疗的关键。肌动蛋白样蛋白 8(ACTL8)是癌症/睾丸抗原家族的一员,与多种癌症的肿瘤生长和患者预后有关。然而,ACTL8 是否参与 LUAD 的发生尚不清楚。本研究旨在探讨 ACTL8 在人 LUAD 细胞中的作用。
方法
采用免疫组织化学和 Western blot 检测 LUAD 组织和细胞系中 ACTL8 的表达。此外,还使用表达 ACTL8 特异性短发夹 RNA 的质粒生成慢病毒,然后感染 A549 和 NCI-H1975 人 LUAD 细胞。研究细胞增殖、迁移、侵袭和凋亡,以及细胞周期进程和上皮间质转化蛋白标志物的表达。还检查了 A549 细胞在裸鼠中的肿瘤生长情况。
结果
结果表明,ACTL8 在 A549 和 NCI-H1975 LUAD 细胞系中高表达。此外,ACTL8 敲低抑制了两种细胞系的增殖、集落形成、细胞周期进程、迁移和侵袭,并增加了凋亡。此外,裸鼠体内实验表明,ACTL8 敲低抑制了 A549 细胞的肿瘤生长。
结论
这些结果表明,ACTL8 在人 LUAD 细胞中发挥致癌作用,ACTL8 可能成为 LUAD 的潜在治疗靶点。
关键点
我们的结果表明,ACTL8 在人 LUAD 细胞中发挥致癌作用,ACTL8 可能成为 LUAD 的潜在治疗靶点。